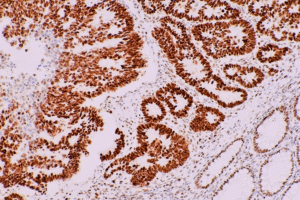
Меланоз кишківника

Статті - сторінка №2
Пікосен Краплі
Меланоз кишківника: чи дійсно він пов’язаний з проносними засобами03.03.2026

Пікосен Капсули
Контактні проносні засоби: як вони працюють і чим відрізняються від осмотичних03.03.2026

Меновазан ПРО, Меновазан Флекспрей
Чому загострюється біль у спині вночі, і як цього уникнути08.08.2025

Меновазан ПРО, Меновазан Саліцилат
Йога та розтяжка для профілактики болю в спині08.08.2025

Меновазан, Меновазан Саліцилат, Меновазан Флекспрей
Масаж при болях у спині: користь чи шкода08.08.2025

Меновазан Саліцилат, Меновазан
Чи може вагітність спричинити ішіас – болі в попереку у майбутніх мам08.08.2025

Меновазан Саліцилат, Меновазан Флекспрей
Ішіас: причини, симптоми і як виникає запалення сідничного нерва08.08.2025

Меновазан, Меновазан ПРО
Біль у спині від сидячого способу життя – як уникнути люмбаго08.08.2025

Гепаринова мазь
Здоровий спосіб життя проти варикозу: чи реально попередити або зупинити процес?17.07.2025

Гепаринова мазь
Серцева недостатність як причина варикозного розширення вен: симптоми та ризики17.07.2025
Показати ще

